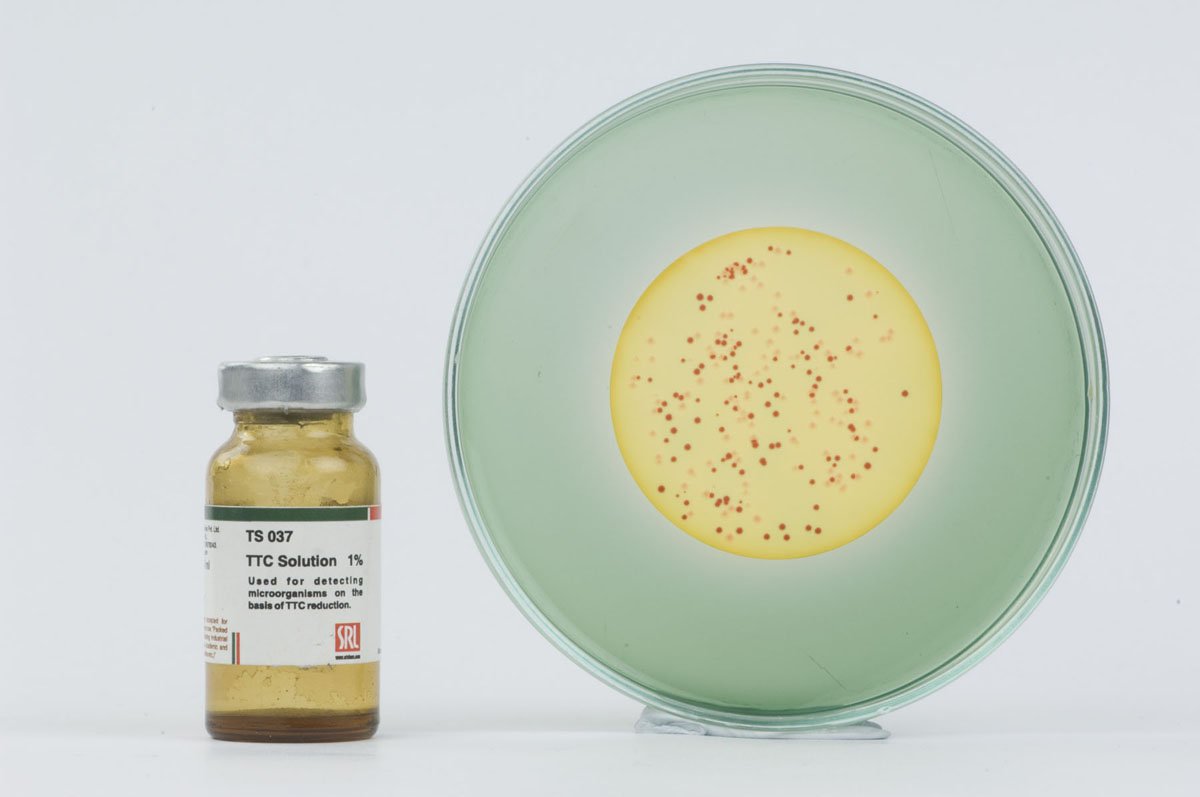

Fournisseur matériels laboratoires et produits chimiques ABTECH est une société de distribution de consommables, verrerie et d’équipement scientifiques des laboratoires.
ABTECH vous propose un choix varié et complet de matériel de laboratoire de bonne qualité et à des prix étudiés. Nos produits comprennent des équipements et du petit matériel de mesure (ph. orp. ec. tds.) ainsi que tous les consommables en verrerie, et autres, (pH-mètres, balances, microscopes, photomètres, conductimètres , oxymètre. Réfractomètres...) des produits chimiques tels que (alcool 96, alcool absolu, acétone .....) Nos équipements et produits sont d’origine européenne ou américaine et sont reconnus dans le monde entier.
ABTECH offre toujours à ses clients le meilleur produit qui a les bonnes particularités en tenant compte des spécificités de la tâche et de l’environnement. Notre sérieux et notre détermination nous obligent continuellement à honorer nos engagements envers nos clients, qui sont entre autres nos partenaires et qui nous poussent davantage à redoubler d’efforts et à maintenir une relation durable basée sur le respect et la confiance mutuelle.
ABTECH met à votre disposition toute son équipe de conseillers et commerciaux pour vous guider dans vos choix de produits, nous assurons en permanence le suivi de vos commandes pour faciliter votre tâche et vous garantir des opérations claires et faciles. C’est en ce sens qu’il nous semble intéressant de susciter votre intérêt à collaborer avec notre équipe et votre adhésion sera sans aucun doute fructueuse.
About Us
✓ Une équipe rigoureuse d’une grande convivialité avec la clientèle
✓ Nos ingénieurs & techniciens sont toujours à votre disposition

ABTECH
Notre Société offre toujours à ses clients le meilleur produit qui a les bonnes particularités en tenant compte des spécificités de la tâche et de l’environnement. Notre sérieux et notre détermination nous obligent continuellement à honorer nos engagements envers nos clients, qui sont entre autres nos partenaires et qui nous poussent davantage à redoubler d’efforts et à maintenir une relation durable basée sur le respect et la confiance mutuelle. Notre Groupe met à votre disposition toute son équipe de conseillers et commerciaux pour vous guider dans vos choix de produits, nous assurons en permanence le suivi de vos commandes pour faciliter votre tâche et vous garantir des opérations claires et faciles. C’est en ce sens qu’il nous semble intéressant de susciter votre intérêt à collaborer avec notre équipe et votre adhésion sera sans aucun doute fructueuse.
notre principal partenaire
SRLchem
SRL was established in the year 1975 to meet the growing demand of Research Chemicals in India and neighbouring countries.
BIOBASE
BIOBASE is a new high-tech enterprise whose business covers biomedical, e-commerce, intelligent manufacturing, scientific equipment, instrument and reagent.
KERN & Sohn
KERN founded his company in 1844 and manufactured the most accurate balances of its time. His business became the core cell of the internationally famous, southern German precision balance manufacturing.
Honeywell
Honeywell ! What We Do ! We Have Been Innovating For More Than 100 Years – And Now We’re Creating What’s Next.
S
Arco Glassware
Arco is proud to be a part of the scientific community for the last six decades, right from their formative stage of learning the basics of Physics, Chemistry, Biology and graduating to enter the most demanding field of knowledge
Milwaukee
Milwaukee's products are used around the world from simple pens and advanced testers through to meters, monitors and controllers. We help you manage parameters including pH, conductivity, salinity, BRIX, temperature and more.
Phenomenex founded nearly 40 years ago, Chromatography the science of separation affects the lives of all of us every day. At Phenomenex, we make consumables like HPLC columns and sample-prep products to help accelerate science and give researchers the tools they require to improve global health and wellbeing.
Trionyx Premier fabricant français d’armoires de sécurité pour produits dangereux et spécialisé dans la manipulation et le stockage des produits dangereux pour l’industrie, le laboratoire et les collectivités . EN 14470-1 / NF X 15-211 / EN 15154-1 et EN 15154-2
Meling's main products include lab / medical refrigerator and freezer, ultra low temperature freezer, blood bank refrigerator, inventory rack/box, professional cold room, and bio-bank management
Interscience développe et fabrique du matériel scientifique innovant pour la microbiologie Depuis 40 ans. Ses produits garantissent des analyses sûres et rapides pour l’industrie agroalimentaire, pharmaceutique, cosmétique, environnementale et la recherche médicale.
Nabertherm propose la plus large gamme de fours standard ainsi que la qualité supérieure En tant que fabricant de fours industriels. Nabertherm « Made in Germany » parle de lui-même
ELICO Ltd is a leading Analytical Instruments Design & Manufacturing Company established in 1960 headquartered in Hyderabad, Andhra Pradesh. It is the first Analytical Instrumentation Company in India and the first Electronics Industry
Nos activites
Notre gamme de produits & répond aux besoins de divers utilisateurs
Equipements de Sécurité
Notre entreprise propose des équipements de contrôle d'accès, tels que des scanners à rayons X pour bagages et des portiques de détection de métaux, conformes aux normes internationales, afin de satisfaire les exigences techniques spécifiques de nos clients.
Produits Chimiques
Notre entreprise offre toujours à ses clients le meilleur produit chimique qui a les bonnes particularités en tenant compte des spécificités de la tâche et de l’environnement
Consommables & Verreries de Laboratoire
Notre gamme de consommables & Verreries de laboratoire répond aux besoins de différents utilisateurs
Milieu de Culture
Notre entreprise offre toujours à ses clients le meilleur produit qui a les bonnes particularités en tenant compte des spécificités de la tâche et de l’environnement
Énergie Photovoltaïque
Notre entreprise propose des maquettes didactiques photovoltaïques équipées de GPRS, conçues pour l'éducation et répondant aux besoins de la formation académique et universitaire.
nos divers equipements,reactifs & solvants

Forced Air Drying Oven (Etuve de Laboratoire )
BIOBASE
-86℃ Ultra-low Temperature Refrigerator (Refrigerateur Ultra Basse Température -86℃)
BIOBASE
High Speed Refrigerated Centrifuge (Centrifugeuse de Paillasse )
BIOBASE
Automatic Ultra-pure water (Distillateur Ultra Pure Automatique )
BIOBASE
Acetonitrile CHROMASOLV™, gradient grade, for HPLC, ≥99.9%
HONEYWELL
Sodium hydroxide solution Volumetric, Reag. Ph. Eur., 0.1 M NaOH (0.1N)
HONEYWELL
Potassium Iodide pure, 99% (Iodure de Potassium pure, 99%)
SRLCHEM
Buffer solution pH 4/7/10 (20 °C) ( Solution tampon pH )
HONEYWELL
Hotte à Flux Laminaire de laboratoire
BIOBASE
Autoaclave Hydrothermal
BIOBASE
Autoclave de stérilisation Vertical
BIOBASE
Micro-Pipette autoclavable Volume Fixe & Variable avec Support rond et linéaire
BIOBASE
Homogénéisateur de laboratoire
BIOBASE
Overhead Stirrer ( Agitateur à Hélice de laboratoire)
BIOBASE
pH/ORP/Temp pH mètre de paillasse avec pile
Milwakee
Evaporateur Rotatif de Laboratoire
BIOBASE
Réactifs De Laboratoire
SRLchem
Large gamme de produits en stock pour votre satisfaction
SRLchem
Milieur de Culture
SRLchem
Biochemicals in 10mg, 25mg, 100mg and 1g packs
SRLchem
Analyseur d’humidité (dessiccateur halogène)
kern-sohn
Balance de Précision & Analytique de Laboratoire
kern-sohn.jpg)
Large gamme des Microscopes à lumière transmise, métallurgiques , polarisants & stéréo
kern-sohn
Poids de contrôle pour balances
kern-sohn